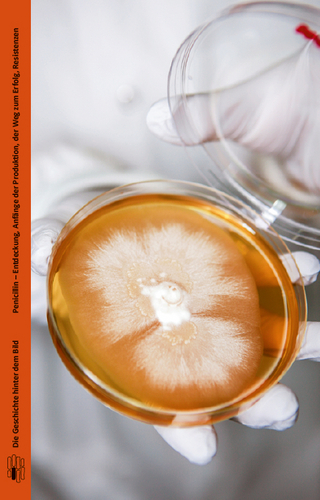
Penicilin

Buch | Softcover
2008
|
Auflage:
2
|
mitp/bhv
ISBN: 9783826674761
CHF 6,90 (inkl. MwSt)
- Titel ist leider vergriffen;
keine Neuauflage